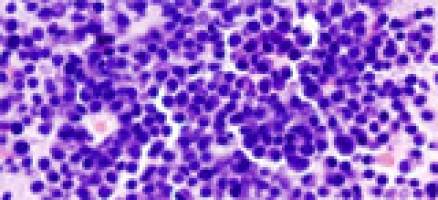
Trial confirms dual benefits of drug for multiple myeloma

science wire
Life Sciences
Results 16051 - 16100 of 17014.
Health - Life Sciences - 04.01.2011
Scientists say ’convergence’ offers potential for revolutionary advances in biomedicine, other fields
A new model for scientific research known as "convergence" offers the potential for revolutionary advances in biomedicine and other areas of science, according to a white paper issued today by 12 leading MIT researchers.
Life Sciences - Health - 04.01.2011
On the trail of a stealthy parasite
About one-third of the human population is infected with a parasite called Toxoplasma gondii, but most of them don?t know it. Though Toxoplasma causes no symptoms in most people, it can be harmful to individuals with suppressed immune systems, and to fetuses whose mothers become infected during pregnancy.
Computer Science - Life Sciences - 03.01.2011
The surprising usefulness of sloppy arithmetic
A computer chip that performs imprecise calculations could process some types of data thousands of times more efficiently than existing chips.
Health - Life Sciences - 03.01.2011

University Park, Pa. Hydrocephalus in Ugandan children and other developing countries is seasonal, linked to farm animals and in part, caused by previous bacterial infection, according to an international team of researchers from Uganda and the United States, who believe that the best approach to this problem is prevention.
Life Sciences - Law - 02.01.2011

CHAMPAIGN, Ill. A newly engineered yeast strain can simultaneously consume two types of sugar from plants to produce ethanol, researchers report.
Life Sciences - Health - 29.12.2010

Bioengineering Professor Scott Delp is the director of a new national center for rehabilitation research at Stanford. The center will focus on using powerful software that simulates human movement to investigate movement disorders and identify the best treatments for patients. "People think about cancer and cardiovascular disease as the major problems associated with aging, but mobility is also very important.
Health - Life Sciences - 29.12.2010
Uncovering the neurobiological basis of general anesthesia
CAMBRIDGE, Mass. The use of general anesthesia is a routine part of surgical operations at hospitals and medical facilities around the world, but the precise biological mechanisms that underlie anesthetic drugs' effects on the brain and the body are only beginning to be understood. A review article in the Dec.
Life Sciences - Health - 26.12.2010

University Park, Pa. The production of high quality chocolate, and the farmers who grow it, will benefit from the recent sequencing and assembly of the chocolate tree genome, according to an international team led by Claire Lanaud of CIRAD, France, with Mark Guiltinan of Penn State, and including scientists from 18 other institutions.
Health - Life Sciences - 23.12.2010
Novartis submits Bexsero , a multi-component meningococcal B vaccine, for regulatory review in Europe
Novartis submits Bexsero , a multi-component meningococcal B vaccine, for regulatory review in Europe Bexsero is the first vaccine with the potential to offer broad coverage against a large number of
Pedagogy - Life Sciences - 23.12.2010

Gaining an insight into the implications of vision loss may now be as simple as donning a pair of 'vision goggles', thanks to a creative new teaching aid.
Life Sciences - 22.12.2010
How past experiences inform future choices
CAMBRIDGE, Mass. Researchers at MIT's Picower Institute for Learning and Memory report for the first time how animals' knowledge obtained through past experiences can subconsciously influence their behavior in new situations. The work, which sheds light on how our past experiences inform our future choices, will be reported on Dec.
Health - Life Sciences - 22.12.2010
Melbourne appoints new head of Research
Life Sciences - 20.12.2010
Photomicrographia: Invisible Worlds
Health - Life Sciences - 20.12.2010

Around 50,000 people in the UK are currently taking lithium. When used appropriately, lithium can be a good way to prevent mood swings caused by bipolar disorder, combating mania, or treating severe and recurring bouts of depression.
Life Sciences - Environment - 19.12.2010
Scientists decipher 3 billion-year-old genomic fossils
CAMBRIDGE, Mass. MIT scientists have created a sort of genomic fossil that shows that the collective genome of all life underwent an enormous expansion about 3 billion years ago, which they're calling the Archean Expansion.
Life Sciences - Mechanical Engineering - 19.12.2010
Engineers take plasmon lasers out of deep freeze
BERKELEY — Researchers at the University of California, Berkeley, have developed a new technique that allows plasmon lasers to operate at room temperature, overcoming a major barrier to practical utilization of the technology.
Life Sciences - 17.12.2010
Scientific expedition completes first double Antarctic crossing in vehicles
Scientific expedition completes first double Antarctic crossing in vehicles The Moon Regan Transantarctic Expedition completed the first there-and-back crossing of Antarctica in wheeled vehicles today.
Health - Life Sciences - 17.12.2010
Planning green light for UKCMRI
Plans to build a world-leading medical research institute at St Pancras in London have been approved by councillors at Camden Town Hall.
History & Archeology - Life Sciences - 15.12.2010

Health - Life Sciences - 15.12.2010
University of Birmingham vaccine technology is rising star in new biotech company
University of Birmingham spin-out company, Hybrid BioSystems Ltd (Hybrid) has today [Wednesday 15 December 2010] announced its merger with Myotec Therapeutics Ltd (Myotec) to form a new biotechnology company that will develop novel treatments for cancer and wasting diseases.
Life Sciences - Economics - 14.12.2010
Food-security idea wins Manchester bioscientists double honours
Health - Life Sciences - 14.12.2010
Older people with severe asthma need higher H1N1 vaccine dose
Media Inquiries news [a] uwhealth (p) org Related Information Department of Medicine UW Health Patient Resources Allergy, Asthma and Immunology Fighting the Flu Stay Connected Madison, Wisconsin - Old
Health - Life Sciences - 14.12.2010

The project has been awarded $500,000 from the Bill and Melinda Gates Foundation, through the World Health Organisation, and aims to be effective against all polio subtypes.
Health - Life Sciences - 14.12.2010

In order to better understand exactly how infectious diseases spread through real-life social networks, a group of Stanford researchers used wireless sensors to track everyone in one American high school during one day of last January's swine flu outbreak.
Life Sciences - 13.12.2010

Dec. AUSTIN, Texas — In the busy world of a honey bee hive, worker bees need their rest in order to best communicate the location of food to their hive mates, research from The University of Texas at Austin shows. "When deprived of sleep, humans typically experience a diminished ability to perform a variety of tasks, including communicating as clearly or as precisely," said Dr. Barrett Klein , a former ecology, evolution and behavior graduate student at the university.
Life Sciences - Environment - 12.12.2010
Unique conservation course celebrates one hundredth graduate
Life Sciences - History & Archeology - 10.12.2010

CHAMPAIGN, lll. In 1851, Lorenzo Langstroth, a Congregational minister and young ladies' school principal based in Philadelphia, revolutionized the practice of beekeeping.
Computer Science - Life Sciences - 10.12.2010

An ant colony is probably the last place you'd expect to find a maths whiz, but researchers from the University of Sydney have shown that the humble ant is not only capable of solving difficult mathematical problems, but is even able to do what few computer algorithms can - adapt the optimal solution to fit a changing problem.
Life Sciences - Health - 09.12.2010

A genome-level study of two closely-related infectious fungi, that can affect maize crops, is offering scientists new ways of understanding how to breed more disease-resistant crop plants.
Health - Life Sciences - 09.12.2010
King’s Health Partners secures largest grant from Alzheimer’s Research Trust
Professor Simon Lovestone, Director of Research, King's Health Partners (KHP), has secured funding of over £1 million from the Alzheimer's Research Trust (ART) which includes ART's largest ever single grant of £715,000. KHP is beginning ambitious new studies that will attempt to identify genes that increase the risk of developing Alzheimer's and develop a blood test to diagnose the disease.
Life Sciences - Health - 09.12.2010
Protein targeted to stop melanoma tumor growth
Hershey, PA - Halting the growth of melanoma tumors by targeting the MIC-1 protein that promotes blood vessel development in tumors may lead to better treatment of this invasive and deadly cancer, according to Penn State College of Medicine researchers in The Foreman Foundation Research Laboratory.
Life Sciences - 09.12.2010

Environment - Life Sciences - 08.12.2010
Ice-age reptile extinctions provide a glimpse of likely responses to human-caused climate change
ANN ARBOR, Mich.—A wave of reptile extinctions on the Greek islands over the past 15,000 years may offer a preview of the way plants and animals will respond as the world rapidly warms due to human-caused climate change, according to a University of Michigan ecologist and his colleagues.
Life Sciences - Chemistry - 08.12.2010
School pupils see life in the lab
Health - Life Sciences - 07.12.2010
Unraveling Alzheimer’s: Simple small molecules could untangle complex disease
Small Molecules for Metal-Amyloid Species in the Brain. Credit: Mi Hee Lim and Joseph J. Braymer Click above image for higher resolution.
Environment - Life Sciences - 07.12.2010
35,000 new species 'sitting in cupboards'
Science 07 Dec 10 Of the estimated 70,000 species of flowering plants yet to be described by scientists, more than half may already have been collected but are lying unknown and unrecognised in collections around the world, a new study suggests.
Health - Life Sciences - 07.12.2010
UW-Madison study of class of ’57 becomes leading research on aging
During the last 50 years, participants in the Wisconsin Longitudinal Study have helped researchers explore the experience of careers, family life, family and education in America.
Life Sciences - 06.12.2010

Life Sciences - Physics - 06.12.2010
A better understanding of nitric oxide toxicity
CAMBRIDGE, Mass. Researchers at MIT, the Japan Synchrotron Radiation Research Institute (JASRI), and the University of California at Davis have succeeded in characterizing the dinitrosyl iron complexes (DNICs) produced during breakdown of the iron-sulphur cluster in Rieske proteins by nitric oxide (NO).
Health - Life Sciences - 06.12.2010
Learning the language of bacteria
Bacteria are among the simplest organisms in nature, but many of them can still talk to each other, using a chemical "language" that is critical to the process of infection.
Health - Life Sciences - 06.12.2010
Professor J Anthony Child and Professor Walter M Gregory (Clinical Trials Research Unit (CTRU), University of Leeds), Professor Gareth J Morgan (formerly at the University of Leeds), together with colleagues from universities and NHS Trusts across the UK, compared two different types of bisphosphonate drug in patients with multiple myeloma.
Life Sciences - Chemistry - 06.12.2010
Synthetic biology team take gold
Life Sciences - Interdisciplinary / All Categories - 06.12.2010
Welcome to the future
Imagine a robot in your home doing the dishes, while safely interacting with you and reacting naturally to your mood.
Environment - Life Sciences - 06.12.2010

Life in a demanding environment with limited resources might be better for the immune system than living in comfort, according to new research from the University of Bristol. Professor Mark Viney and colleagues compared the immune function of wild mice who have to find their own food with that of mice bred in captivity who have all food and lodging provided for them.
Life Sciences - Chemistry - 05.12.2010
Synthetic biology team take gold
Health - Life Sciences - 05.12.2010

A gene that can cause congenital heart defects has been identified by a team of scientists, including a group from Princeton University. The discovery could lead to new treatments for those affected by the conditions brought on by the birth defect.
Health - Life Sciences - 03.12.2010

Chemistry - Life Sciences - 03.12.2010
'Gatekeepers' open bugs to attack
Science Cath Harris | 03 Dec 10 Bacteria have a canny way of protecting themselves from attack by toxic chemicals, aiding their survival and development.
Health - Life Sciences - 02.12.2010
Wisconsin Institutes for Discovery facility opens on UW-Madison campus
Twin research institutes and a space designed for all to engage in science opened Thursday (Dec. 2) on the University of Wisconsin-Madison campus.
Life Sciences - Environment - 02.12.2010

University of Manchester scientists have helped identify the key trigger mechanism in the 'internal clocks' of animals which means they are prepared for the season whether snow comes in November or the sun shines in March. The research team, led by Dr Hugues Dardente and Professor David Hazlerigg at the University of Aberdeen and including Professor Andrew Loudon at Manchester's Faculty of Life Sciences, has pinpointed the 'switch' controlling seasonal hormone production, based on the changing daily cycle of light and darkness.
Life Sciences - Mar 27
Understanding the Brain - TU Ilmenau's EU EMBRACE Project Nominated for European Excellence Award
Understanding the Brain - TU Ilmenau's EU EMBRACE Project Nominated for European Excellence Award
Social Sciences - Mar 27
A manual addresses, for the first time in Spain, child and adolescent sexual exploitation
A manual addresses, for the first time in Spain, child and adolescent sexual exploitation

Environment - Mar 26
Changing vegetation in thawing permafrost increases emissions of greenhouse gases
Changing vegetation in thawing permafrost increases emissions of greenhouse gases

Environment - Mar 26
University of Manchester hits major sustainability milestone, with Main Campus becoming 100% 'Zero Landfill'
University of Manchester hits major sustainability milestone, with Main Campus becoming 100% 'Zero Landfill'

Social Sciences - Mar 26
"It would be naive to believe that a social media ban will solve all problems"
"It would be naive to believe that a social media ban will solve all problems"

Health - Mar 26
Earlier detection, better outcomes: Irish researchers target rising bowel cancer rates with new blood test
Earlier detection, better outcomes: Irish researchers target rising bowel cancer rates with new blood test
Environment - Mar 26
UK must improve energy efficiency to end 50 years of policy failure and prevent future energy crises, study argues
UK must improve energy efficiency to end 50 years of policy failure and prevent future energy crises, study argues

Mathematics - Mar 26
From Materials to Medical Imaging, Fonseca's Work Shapes the Future of Innovation
From Materials to Medical Imaging, Fonseca's Work Shapes the Future of Innovation









